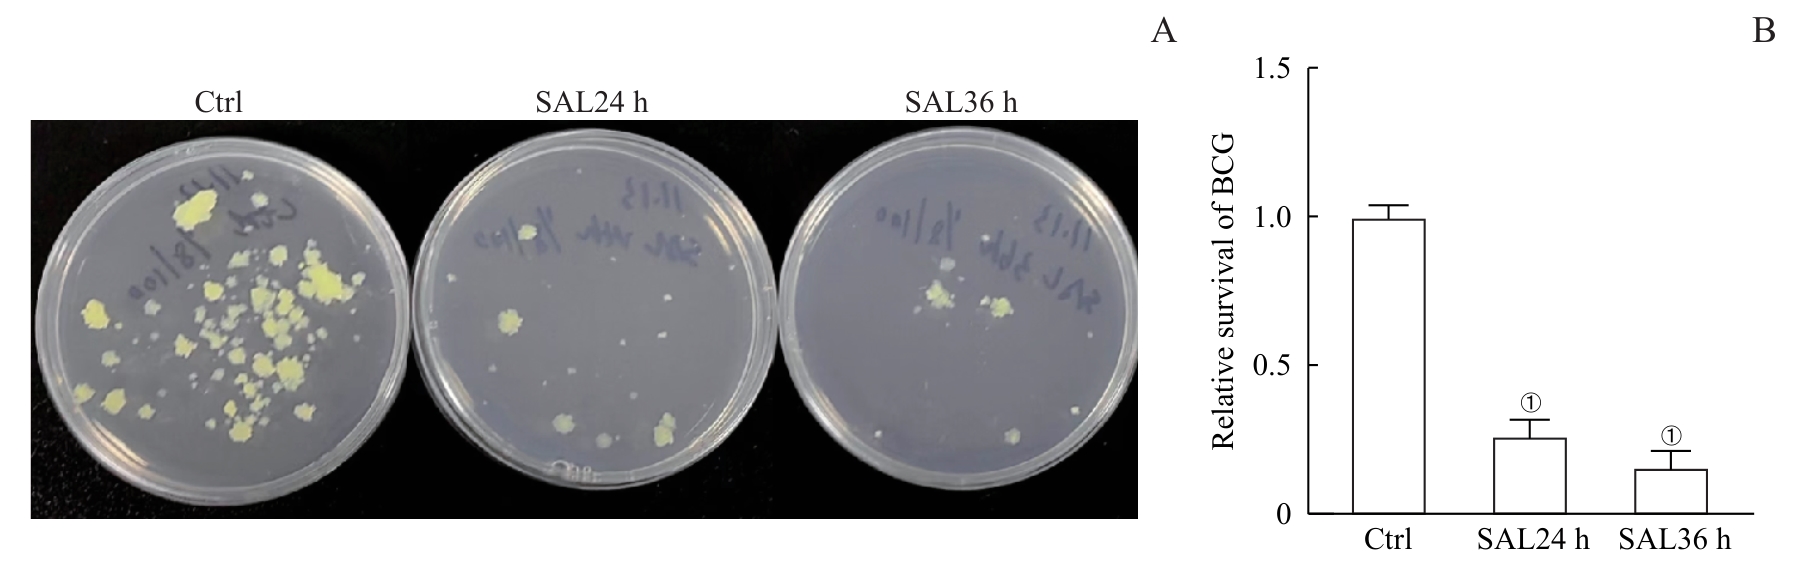

红景天苷对卡介苗感染的巨噬细胞免疫功能的影响
Effect of salidroside on the immune function of BCG-infected macrophages
Note: A. Images show CFU of BCG survival in macrophages after 24 h and 36 h of SAL pretreatment. B. Statistical analysis of the relative amount of BCG survival in macrophages after 24 h and 36 h of SAL pretreatment. ①P<0.001, compared with the control group.